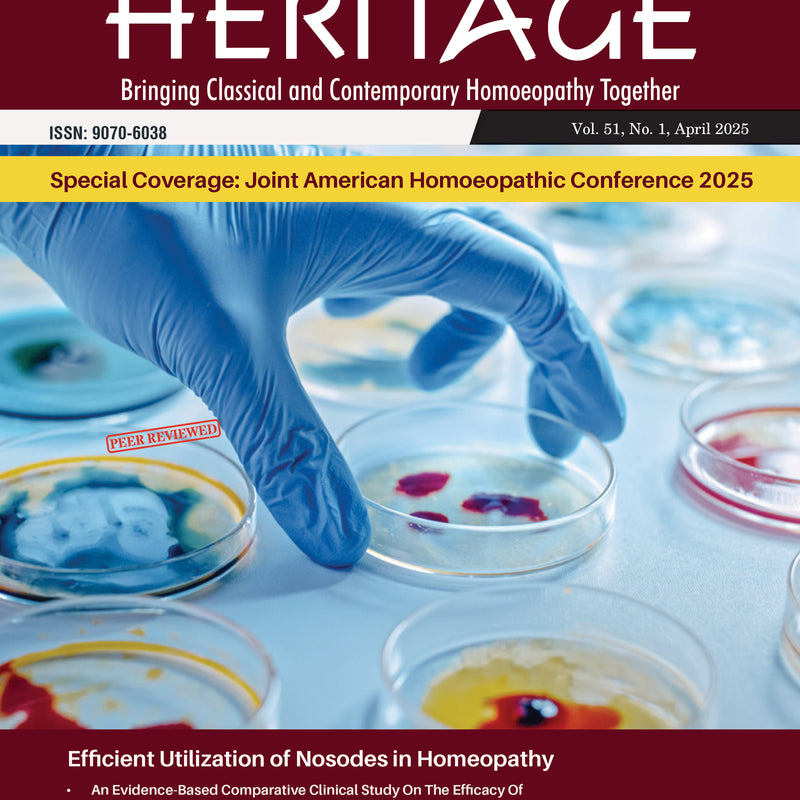
The Homoeopathic Heritage (APRIL 2025), by
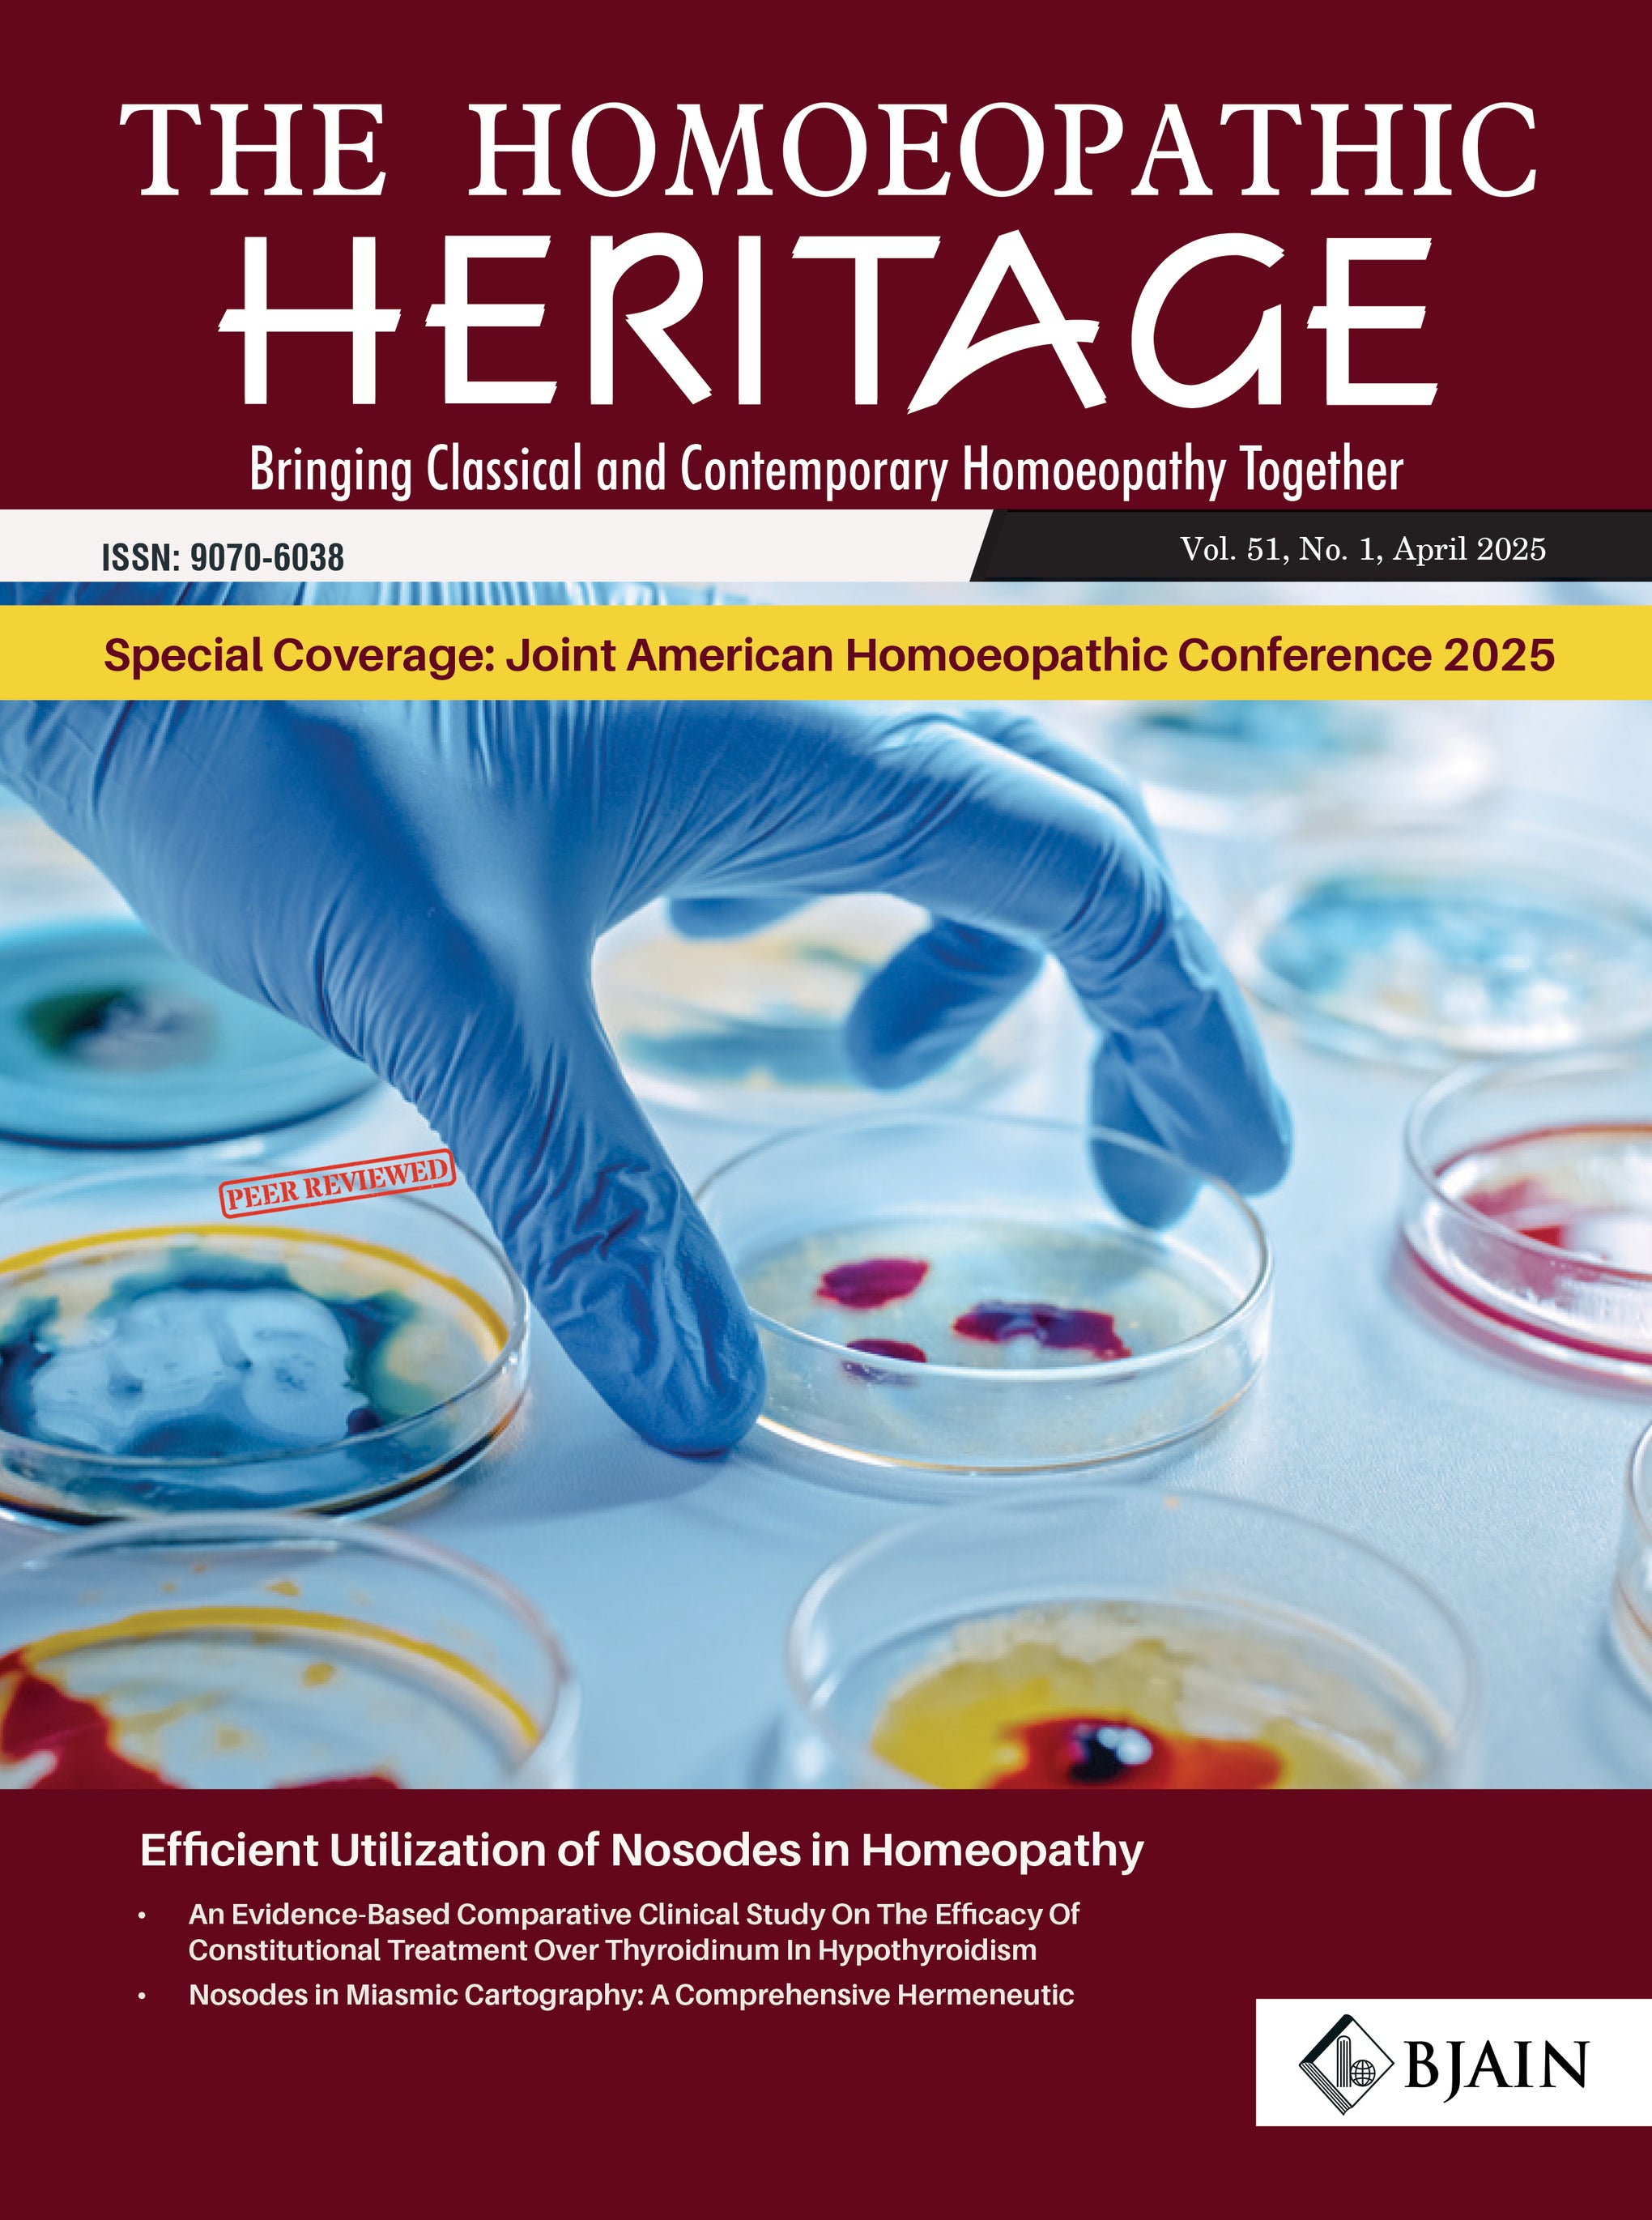

- Made With Love
- Made With Love
- Made With Love
- Made With Love
- Made With Love
Recommended Products

The Homoeopathic Heritage (APRIL 2025), by
Rs. 295
Rs. 295
Your cart is currently empty
Start typing to see results
Your wishlist is currently empty
Your list is currently empty